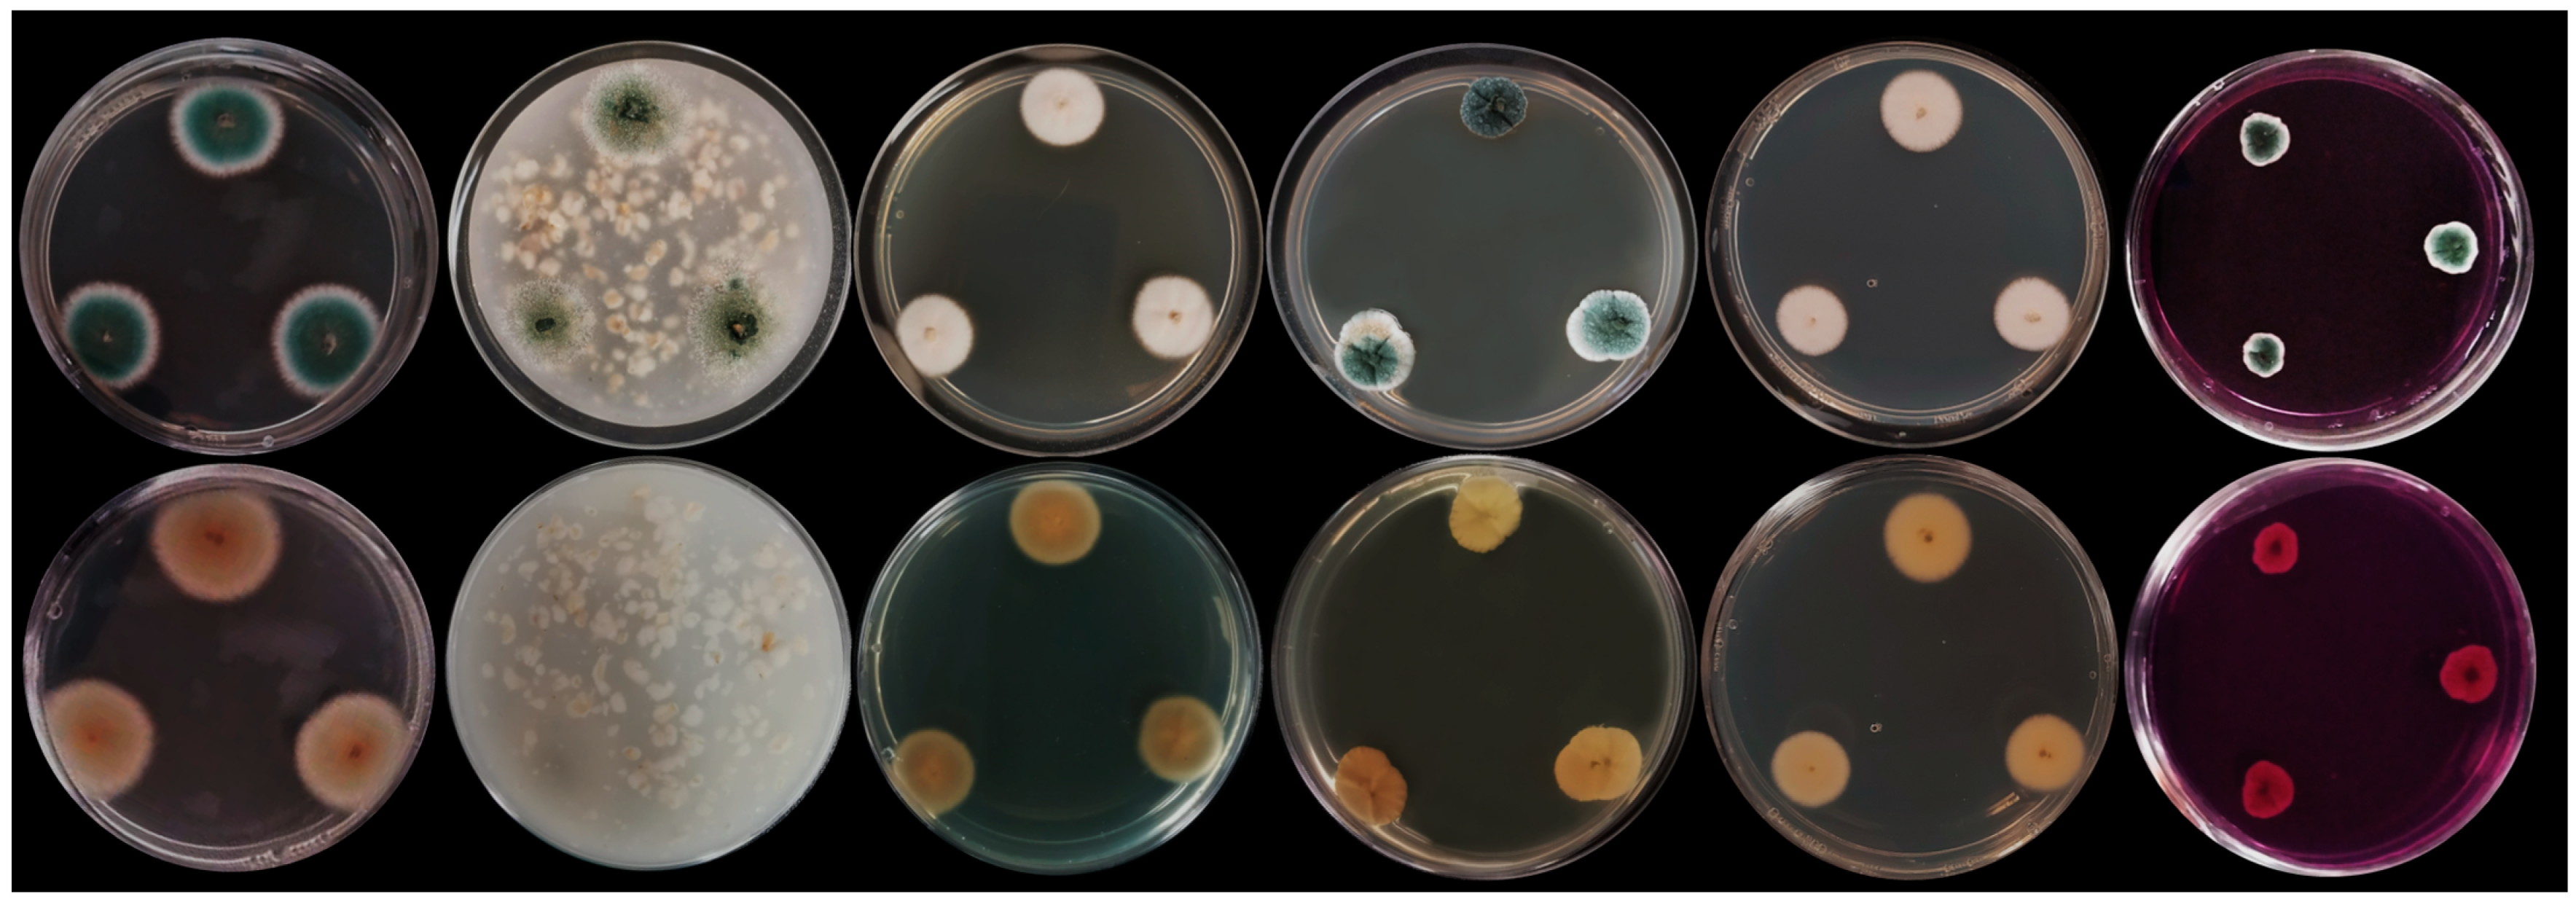
Applsci 14 10600 g002

Morpho-Molecular and Genomic Characterization of Penicillium mexicanum Isolates Retrieved from a Forsaken Gold Mine
Abstract
1. Introduction
2. Materials and Methods
2.1. Fungal Isolation
2.2. Morphological Characterization
2.3. Phylogenetic Characterization
2.4. Genomic Characterization
3. Results and Discussion
3.1. Phylogenetic Analysis
3.2. Morphological Analysis
3.3. Genomic Characteristics
4. Conclusions
Supplementary Materials
Author Contributions
Funding
Institutional Review Board Statement
Informed Consent Statement
Data Availability Statement
Conflicts of Interest
References
- Ferreira da Silva, E.; Zhang, C.; Serrano Pinto, L.; Patinha, C.; Reis, P. Hazard Assessment on Arsenic and Lead in Soils of Castromil Gold Mining Area, Portugal. Appl. Geochem. 2004, 19, 887–898. [Google Scholar] [CrossRef]
- Donato, D.B.; Nichols, O.; Possingham, H.; Moore, M.; Ricci, P.F.; Noller, B.N. A Critical Review of the Effects of Gold Cyanide-Bearing Tailings Solutions on Wildlife. Environ. Int. 2007, 33, 974–984. [Google Scholar] [CrossRef] [PubMed]
- Ngole-Jeme, V.M.; Fantke, P. Ecological and Human Health Risks Associated with Abandoned Gold Mine Tailings Contaminated Soil. PLoS ONE 2017, 12, e0172517. [Google Scholar] [CrossRef] [PubMed]
- Crognale, S.; D’Annibale, A.; Pesciaroli, L.; Stazi, S.R.; Petruccioli, M. Fungal Community Structure and As-Resistant Fungi in a Decommissioned Gold Mine Site. Front. Microbiol. 2017, 8, 2202. [Google Scholar] [CrossRef] [PubMed]
- Hyde, K.D.; Xu, J.; Rapior, S.; Jeewon, R.; Lumyong, S.; Niego, A.G.T.; Abeywickrama, P.D.; Aluthmuhandiram, J.V.S.; Brahamanage, R.S.; Brooks, S.; et al. The Amazing Potential of Fungi: 50 Ways We Can Exploit Fungi Industrially. Fungal Divers. 2019, 97, 1–136. [Google Scholar] [CrossRef]
- Lücking, R.; Aime, M.C.; Robbertse, B.; Miller, A.N.; Aoki, T.; Ariyawansa, H.A.; Cardinali, G.; Crous, P.W.; Druzhinina, I.S.; Geiser, D.M.; et al. Fungal Taxonomy and Sequence-Based Nomenclature. Nat. Microbiol. 2021, 6, 540–548. [Google Scholar] [CrossRef]
- Corbu, V.M.; Gheorghe-Barbu, I.; Dumbravă, A.Ș.; Vrâncianu, C.O.; Șesan, T.E. Current Insights in Fungal Importance—A Comprehensive Review. Microorganisms 2023, 11, 1384. [Google Scholar] [CrossRef]
- Niego, A.G.T.; Lambert, C.; Mortimer, P.; Thongklang, N.; Rapior, S.; Grosse, M.; Schrey, H.; Charria-Girón, E.; Walker, A.; Hyde, K.D.; et al. The Contribution of Fungi to the Global Economy. Fungal Divers. 2023, 121, 95–137. [Google Scholar] [CrossRef]
- Houbraken, J.; Kocsubé, S.; Visagie, C.M.; Yilmaz, N.; Wang, X.-C.; Meijer, M.; Kraak, B.; Hubka, V.; Bensch, K.; Samson, R.A.; et al. Classification of Aspergillus, Penicillium, Talaromyces and Related Genera (Eurotiales): An Overview of Families, Genera, Subgenera, Sections, Series and Species. Stud. Mycol. 2020, 95, 5–169. [Google Scholar] [CrossRef]
- Bhunjun, C.S.; Chen, Y.J.; Phukhamsakda, C.; Boekhout, T.; Groenewald, J.Z.; Mckenzie, E.H.C.; Francisco, E.C.; Frisvad, J.C.; Groenewald, M.; Hurdeal, V.G.; et al. What Are the 100 Most Cited Fungal Genera? Stud. Mycol. 2024, 108, 1–412. [Google Scholar] [CrossRef]
- Visagie, C.M.; Yilmaz, N.; Kocsubé, S.; Frisvad, J.C.; Hubka, V.; Samson, R.A.; Houbraken, J. A Review of Recently Introduced Aspergillus, Penicillium, Talaromyces and Other Eurotiales Species. Stud. Mycol. 2024, 107, 1–66. [Google Scholar] [CrossRef] [PubMed]
- Valix, M.; Tang, J.Y.; Malik, R. Heavy Metal Tolerance of Fungi. Miner. Eng. 2001, 14, 499–505. [Google Scholar] [CrossRef]
- Zehra, A.; Dubey, M.K.; Meena, M.; Aamir, M.; Patel, C.B.; Upadhyay, R.S. Role of Penicillium Species in Bioremediation Processes. In New and Future Developments in Microbial Biotechnology and Bioengineering; Gupta, V.K., Rodriguez-Couto, S., Eds.; Elsevier: Amsterdam, The Netherlands, 2018; pp. 247–260. ISBN 978-0-444-63501-3. [Google Scholar]
- Bhandari, Y.; Varma, S.; Sawant, A.; Beemagani, S.; Jaiswal, N.; Chaudhari, B.P.; Vamkudoth, K.R. Biosynthesis of Gold Nanoparticles by Penicillium rubens and Catalytic Detoxification of Ochratoxin A and Organic Dye Pollutants. Int. Microbiol. 2023, 26, 765–780. [Google Scholar] [CrossRef] [PubMed]
- Coelho, E.; Reis, T.A.; Cotrim, M.; Rizzutto, M.; Corrêa, B. Bioremediation of Water Contaminated with Uranium Using Penicillium piscarium. Biotechnol. Prog. 2020, 36, e30322. [Google Scholar] [CrossRef] [PubMed]
- Glukhova, L.B.; Frank, Y.A.; Danilova, E.V.; Avakyan, M.R.; Banks, D.; Tuovinen, O.H.; Karnachuk, O.V. Isolation, Characterization, and Metal Response of Novel, Acid-Tolerant Penicillium spp. from Extremely Metal-Rich Waters at a Mining Site in Transbaikal (Siberia, Russia). Microb. Ecol. 2018, 76, 911–924. [Google Scholar] [CrossRef]
- Sánchez-Castellón, J.; Urango-Cárdenas, I.; Enamorado-Montes, G.; Burgos-Nuñez, S.; Marrugo-Negrete, J.; Díez, S. Removal of Mercury, Cadmium, and Lead Ions by Penicillium sp. Front. Environ. Chem. 2022, 2, 795632. [Google Scholar] [CrossRef]
- Sheikhloo, Z.; Salouti, M. Intracellular Biosynthesis of Gold Nanoparticles by the Fungus Penicillium chrysogenum. Int. J. Nanosci. Nanotechnol. 2011, 7, 102–105. [Google Scholar] [CrossRef]
- Magdi, H.M.; Bhushan, B. Extracellular Biosynthesis and Characterization of Gold Nanoparticles Using the Fungus Penicillium chrysogenum. Microsyst. Technol. 2015, 21, 2279–2285. [Google Scholar] [CrossRef]
- Trovão, J.; Soares, F.; Paiva, D.S.; Pratas, J.; Portugal, A. A Snapshot of the Microbiome of a Portuguese Abandoned Gold Mining Area. Appl. Sci. 2024, 14, 226. [Google Scholar] [CrossRef]
- Trovão, J.; Portugal, A.; Soares, F.; Paiva, D.S.; Mesquita, N.; Coelho, C.; Pinheiro, A.C.; Catarino, L.; Gil, F.; Tiago, I. Fungal Diversity and Distribution across Distinct Biodeterioration Phenomena in Limestone Walls of the Old Cathedral of Coimbra, UNESCO World Heritage Site. Int. Biodet. Biodegr. 2019, 142, 91–102. [Google Scholar] [CrossRef]
- White, T.; Bruns, T.; Lee, S.; Taylor, J.; Innis, M.; Gelfand, D.; Sninsky, J. Amplification and Direct Sequencing of Fungal Ribosomal RNA Genes for Phylogenetics. In PCR Protocols: A Guide to Methods and Applications; Innis, M., Gelfand, D., Sninsky, J.J., White, T.J., Eds.; Academic Press: New York, NY, USA, 1990; Volume 31, pp. 315–322. [Google Scholar] [CrossRef]
- Gardes, M.; Bruns, T.D. ITS Primers with Enhanced Specificity for Basidiomycetes—Application to the Identification of Mycorrhizae and Rusts. Mol. Ecol. 1993, 2, 113–118. [Google Scholar] [CrossRef] [PubMed]
- Liu, Y.J.; Whelen, S.; Hall, B.D. Phylogenetic Relationships among Ascomycetes: Evidence from an RNA Polymerse II Subunit. Mol. Biol. Evol. 1999, 16, 1799–1808. [Google Scholar] [CrossRef] [PubMed]
- Hong, S.-B.; Cho, H.-S.; Shin, H.-D.; Frisvad, J.C.; Samson, R.A. Novel Neosartorya Species Isolated from Soil in Korea. Int. J. Syst. Evol. Microbiol. 2006, 56, 477–486. [Google Scholar] [CrossRef] [PubMed]
- Glass, N.L.; Donaldson, G.C. Development of Primer Sets Designed for Use with the PCR to Amplify Conserved Genes from Filamentous Ascomycetes. Appl. Environ. Microbiol. 1995, 61, 1323–1330. [Google Scholar] [CrossRef]
- Trovão, J.; Soares, F.; Tiago, I.; Portugal, A. Talaromyces Saxoxalicus sp. Nov., Isolated from the Limestone Walls of the Old Cathedral of Coimbra, Portugal. Int. J. Syst. Evol. Microbiol. 2021, 71, 005175. [Google Scholar] [CrossRef]
- Altschul, S.F.; Madden, T.L.; Schäffer, A.A.; Zhang, J.; Zhang, Z.; Miller, W.; Lipman, D.J. Gapped BLAST and PSI-BLAST: A New Generation of Protein Database Search Programs. Nucleic Acids Res. 1997, 25, 3389–3402. [Google Scholar] [CrossRef]
- Torres-Garcia, D.; Gené, J.; García, D. New and Interesting Species of Penicillium (Eurotiomycetes, Aspergillaceae) in Freshwater Sediments from Spain. MycoKeys 2022, 86, 103–145. [Google Scholar] [CrossRef]
- Lee, J.-M.; Cha, J.-E.; Yoon, Y.-S.; Eom, A.-H. Penicillium mexicanum: An Unrecorded Fungal Species Isolated from Air Samples Collected in Korea. Korean J. Mycol. 2023, 51, 127–133. [Google Scholar] [CrossRef]
- Katoh, K.; Standley, D.M. MAFFT Multiple Sequence Alignment Software Version 7: Improvements in Performance and Usability. Mol. Biol. Evol. 2013, 30, 772–780. [Google Scholar] [CrossRef]
- Okonechnikov, K.; Golosova, O.; Fursov, M. UGENE team Unipro UGENE: A Unified Bioinformatics Toolkit. Bioinformatics 2012, 28, 1166–1167. [Google Scholar] [CrossRef]
- Gouy, M.; Guindon, S.; Gascuel, O. SeaView Version 4: A Multiplatform Graphical User Interface for Sequence Alignment and Phylogenetic Tree Building. Mol. Biol. Evol. 2010, 27, 221–224. [Google Scholar] [CrossRef] [PubMed]
- Kalyaanamoorthy, S.; Minh, B.Q.; Wong, T.K.F.; von Haeseler, A.; Jermiin, L.S. ModelFinder: Fast Model Selection for Accurate Phylogenetic Estimates. Nat. Methods 2017, 14, 587–589. [Google Scholar] [CrossRef] [PubMed]
- Trifinopoulos, J.; Nguyen, L.-T.; von Haeseler, A.; Minh, B.Q. W-IQ-TREE: A Fast Online Phylogenetic Tool for Maximum Likelihood Analysis. Nucleic Acids Res. 2016, 44, W232–W235. [Google Scholar] [CrossRef] [PubMed]
- Guindon, S.; Dufayard, J.-F.; Lefort, V.; Anisimova, M.; Hordijk, W.; Gascuel, O. New Algorithms and Methods to Estimate Maximum-Likelihood Phylogenies: Assessing the Performance of PhyML 3.0. Syst. Biol. 2010, 59, 307–321. [Google Scholar] [CrossRef] [PubMed]
- Anisimova, M.; Gil, M.; Dufayard, J.-F.; Dessimoz, C.; Gascuel, O. Survey of Branch Support Methods Demonstrates Accuracy, Power, and Robustness of Fast Likelihood-Based Approximation Schemes. Syst. Biol. 2011, 60, 685–699. [Google Scholar] [CrossRef]
- Jalili, V.; Afgan, E.; Gu, Q.; Clements, D.; Blankenberg, D.; Goecks, J.; Taylor, J.; Nekrutenko, A. The Galaxy Platform for Accessible, Reproducible and Collaborative Biomedical Analyses: 2020 Update. Nucleic Acids Res. 2020, 48, W395–W402. [Google Scholar] [CrossRef]
- De Coster, W.; D’Hert, S.; Schultz, D.T.; Cruts, M.; Van Broeckhoven, C. NanoPack: Visualizing and Processing Long-Read Sequencing Data. Bioinformatics 2018, 34, 2666–2669. [Google Scholar] [CrossRef]
- Kolmogorov, M.; Yuan, J.; Lin, Y.; Pevzner, P.A. Assembly of Long, Error-Prone Reads Using Repeat Graphs. Nat. Biotechnol. 2019, 37, 540–546. [Google Scholar] [CrossRef]
- Gurevich, A.; Saveliev, V.; Vyahhi, N.; Tesler, G. QUAST: Quality Assessment Tool for Genome Assemblies. Bioinformatics 2013, 29, 1072–1075. [Google Scholar] [CrossRef]
- Simão, F.A.; Waterhouse, R.M.; Ioannidis, P.; Kriventseva, E.V.; Zdobnov, E.M. BUSCO: Assessing Genome Assembly and Annotation Completeness with Single-Copy Orthologs. Bioinformatics 2015, 31, 3210–3212. [Google Scholar] [CrossRef]
- Kriventseva, E.V.; Kuznetsov, D.; Tegenfeldt, F.; Manni, M.; Dias, R.; Simão, F.A.; Zdobnov, E.M. OrthoDB V10: Sampling the Diversity of Animal, Plant, Fungal, Protist, Bacterial and Viral Genomes for Evolutionary and Functional Annotations of Orthologs. Nucleic Acids Res. 2019, 47, D807–D811. [Google Scholar] [CrossRef] [PubMed]
- Seemann, T. Barrnap 0.7: Rapid Ribosomal RNA Prediction. 2013. Available online: https://github.com/tseemann/barrnap (accessed on 8 October 2024).
- Laslett, D.; Canback, B. ARAGORN, a Program to Detect tRNA Genes and tmRNA Genes in Nucleotide Sequences. Nucleic Acids Res. 2004, 32, 11–16. [Google Scholar] [CrossRef] [PubMed]
- Flynn, J.M.; Hubley, R.; Goubert, C.; Rosen, J.; Clark, A.G.; Feschotte, C.; Smit, A.F. RepeatModeler2 for Automated Genomic Discovery of Transposable Element Families. Proc. Nat. Acad. Sci. USA 2020, 117, 9451–9457. [Google Scholar] [CrossRef] [PubMed]
- Smit, A.; Hubley, R.; Green, P. RepeatMasker Open-4.0. (2013–2015). Available online: http://www.repeatmasker.org (accessed on 8 October 2024).
- Cantalapiedra, C.P.; Hernández-Plaza, A.; Letunic, I.; Bork, P.; Huerta-Cepas, J. eggNOG-Mapper v2: Functional Annotation, Orthology Assignments, and Domain Prediction at the Metagenomic Scale. Mol. Biol. Evol. 2021, 38, 5825–5829. [Google Scholar] [CrossRef]
- Jones, P.; Binns, D.; Chang, H.-Y.; Fraser, M.; Li, W.; McAnulla, C.; McWilliam, H.; Maslen, J.; Mitchell, A.; Nuka, G.; et al. InterProScan 5: Genome-Scale Protein Function Classification. Bioinformatics 2014, 30, 1236–1240. [Google Scholar] [CrossRef]
- Blum, M.; Chang, H.-Y.; Chuguransky, S.; Grego, T.; Kandasaamy, S.; Mitchell, A.; Nuka, G.; Paysan-Lafosse, T.; Qureshi, M.; Raj, S.; et al. The InterPro Protein Families and Domains Database: 20 Years On. Nucleic Acids Res. 2021, 49, D344–D354. [Google Scholar] [CrossRef]
- Conesa, A.; Götz, S.; García-Gómez, J.M.; Terol, J.; Talón, M.; Robles, M. Blast2GO: A Universal Tool for Annotation, Visualization and Analysis in Functional Genomics Research. Bioinformatics 2005, 21, 3674–3676. [Google Scholar] [CrossRef]
- Götz, S.; García-Gómez, J.M.; Terol, J.; Williams, T.D.; Nagaraj, S.H.; Nueda, M.J.; Robles, M.; Talón, M.; Dopazo, J.; Conesa, A. High-Throughput Functional Annotation and Data Mining with the Blast2GO Suite. Nucleic Acids Res. 2008, 36, 3420–3435. [Google Scholar] [CrossRef]
- Zheng, J.; Ge, Q.; Yan, Y.; Zhang, X.; Huang, L.; Yin, Y. dbCAN3: Automated Carbohydrate-Active Enzyme and Substrate Annotation. Nucleic Acids Res. 2023, 51, W115–W121. [Google Scholar] [CrossRef]
- Blin, K.; Shaw, S.; Augustijn, H.E.; Reitz, Z.L.; Biermann, F.; Alanjary, M.; Fetter, A.; Terlouw, B.R.; Metcalf, W.W.; Helfrich, E.J.N.; et al. antiSMASH 7.0: New and Improved Predictions for Detection, Regulation, Chemical Structures and Visualisation. Nucleic Acids Res. 2023, 51, W46–W50. [Google Scholar] [CrossRef]
- Kanehisa, M.; Sato, Y.; Morishima, K. BlastKOALA and GhostKOALA: KEGG Tools for Functional Characterization of Genome and Metagenome Sequences. J. Mol. Biol. 2016, 428, 726–731. [Google Scholar] [CrossRef] [PubMed]
- Song, X.; Li, Y.; Stirling, E.; Zhao, K.; Wang, B.; Zhu, Y.; Luo, Y.; Xu, J.; Ma, B. AsgeneDB: A Curated Orthology Arsenic Metabolism Gene Database and Computational Tool for Metagenome Annotation. NAR Genom. Bioinform. 2022, 4, lqac080. [Google Scholar] [CrossRef]
- Buchfink, B.; Xie, C.; Huson, D.H. Fast and Sensitive Protein Alignment Using DIAMOND. Nat. Methods 2015, 12, 59–60. [Google Scholar] [CrossRef]
- Tang, D.; Chen, M.; Huang, X.; Zhang, G.; Zeng, L.; Zhang, G.; Wu, S.; Wang, Y. SRplot: A Free Online Platform for Data Visualization and Graphing. PLoS ONE 2023, 18, e0294236. [Google Scholar] [CrossRef]
- Visagie, C.M.; Hirooka, Y.; Tanney, J.B.; Whitfield, E.; Mwange, K.; Meijer, M.; Amend, A.S.; Seifert, K.A.; Samson, R.A. Aspergillus, Penicillium and Talaromyces Isolated from House Dust Samples Collected Around the World. Stud. Mycol. 2014, 78, 63–139. [Google Scholar] [CrossRef]
- Park, M.S.; Oh, S.-Y.; Fong, J.J.; Houbraken, J.; Lim, Y.W. The Diversity and Ecological Roles of Penicillium in Intertidal Zones. Sci. Rep. 2019, 9, 13540. [Google Scholar] [CrossRef]
- Wijayawardene, N.N.; Phillips, A.J.L.; Tibpromma, S.; Dai, D.Q.; Selbmann, L.; Monteiro, J.S.; Aptroot, A.; Flakus, A.; Rajeshkumar, K.C.; Coleine, C. Looking for the Undiscovered Asexual Taxa: Case Studies from Lesser Studied Life Modes and Habitats. Mycosphere 2021, 12, 1290–1333. [Google Scholar] [CrossRef]
- Coleine, C.; Stajich, J.E.; Selbmann, L. Fungi Are Key Players in Extreme Ecosystems. Trends Ecol. Evol. 2022, 37, 517–528. [Google Scholar] [CrossRef]
- Petersen, C.; Sørensen, T.; Nielsen, M.R.; Sondergaard, T.E.; Sørensen, J.L.; Fitzpatrick, D.A.; Frisvad, J.C.; Nielsen, K.L. Comparative Genomic Study of the Penicillium Genus Elucidates a Diverse Pangenome and 15 Lateral Gene Transfer Events. IMA Fungus 2023, 14, 3. [Google Scholar] [CrossRef]
- Visagie, C.M.; Magistà, D.; Ferrara, M.; Balocchi, F.; Duong, T.A.; Eichmeier, A.; Gramaje, D.; Aylward, J.; Baker, S.E.; Barnes, I.; et al. IMA Genome-F18. IMA Fungus 2023, 14, 21. [Google Scholar] [CrossRef]
- Roxo, I.; Amaral, A.; Portugal, A.; Trovão, J. Draft Genome Sequence and Comparative Genomic Analysis of Penicillium pancosmium MUM 23.27 Isolated from Raw Honey. Arch. Microbiol. 2024, 206, 36. [Google Scholar] [CrossRef] [PubMed]
- Coleine, C.; Masonjones, S.; Sterflinger, K.; Onofri, S.; Selbmann, L.; Stajich, J.E. Peculiar Genomic Traits in the Stress-Adapted Cryptoendolithic Antarctic Fungus Friedmanniomyces endolithicus. Fungal Biol. 2020, 124, 458–467. [Google Scholar] [CrossRef] [PubMed]
- Paiva, D.S.; Fernandes, L.; Portugal, A.; Trovão, J. First Genome Sequence of the Microcolonial Black Fungus Saxispiralis lemnorum MUM 23.14: Insights into the Unique Genomic Traits of the Aeminiaceae Family. Microorganisms 2024, 12, 104. [Google Scholar] [CrossRef] [PubMed]
- Pao, S.S.; Paulsen, I.T.; Saier, M.H. Major Facilitator Superfamily. Microbiol. Mol. Biol. Rev. 1998, 62, 1–34. [Google Scholar] [CrossRef] [PubMed]
- Vaccaro, F.A.; Drennan, C.L. The Role of Nucleoside Triphosphate Hydrolase Metallochaperones in Making Metalloenzymes. Metallomics 2022, 14, mfac030. [Google Scholar] [CrossRef]
- Zhang, S.; Shi, G.; Xu, X.; Guo, X.; Li, S.; Li, Z.; Wu, Q.; Yin, W.-B. Global Analysis of Natural Products Biosynthetic Diversity Encoded in Fungal Genomes. J. Fungi 2024, 10, 653. [Google Scholar] [CrossRef]
- Morales-Oyervides, L.; Ruiz-Sánchez, J.P.; Oliveira, J.C.; Sousa-Gallagher, M.J.; Méndez-Zavala, A.; Giuffrida, D.; Dufossé, L.; Montañez, J. Biotechnological Approaches for the Production of Natural Colorants by Talaromyces/Penicillium: A Review. Biotechnol. Adv. 2020, 43, 107601. [Google Scholar] [CrossRef]
- Afroz Toma, M.; Rahman, M.H.; Rahman, M.S.; Arif, M.; Nazir, K.H.M.N.H.; Dufossé, L. Fungal Pigments: Carotenoids, Riboflavin, and Polyketides with Diverse Applications. J. Fungi 2023, 9, 454. [Google Scholar] [CrossRef]
- Bignell, E.; Cairns, T.C.; Throckmorton, K.; Nierman, W.C.; Keller, N.P. Secondary Metabolite Arsenal of an Opportunistic Pathogenic Fungus. Philos. Trans. R. Soc. Lond. B Biol. Sci. 2016, 371, 20160023. [Google Scholar] [CrossRef]
- Ries, M.I.; Ali, H.; Lankhorst, P.P.; Hankemeier, T.; Bovenberg, R.A.L.; Driessen, A.J.M.; Vreeken, R.J. Novel Key Metabolites Reveal Further Branching of the Roquefortine/Meleagrin Biosynthetic Pathway. J. Biol. Chem. 2013, 288, 37289–37295. [Google Scholar] [CrossRef]
- Banani, H.; Marcet-Houben, M.; Ballester, A.-R.; Abbruscato, P.; González-Candelas, L.; Gabaldón, T.; Spadaro, D. Genome Sequencing and Secondary Metabolism of the Postharvest Pathogen Penicillium griseofulvum. BMC Genom. 2016, 17, 19. [Google Scholar] [CrossRef] [PubMed]
- Garello, M.; Piombo, E.; Buonsenso, F.; Prencipe, S.; Valente, S.; Meloni, G.R.; Marcet-Houben, M.; Gabaldón, T.; Spadaro, D. Several Secondary Metabolite Gene Clusters in the Genomes of Ten Penicillium spp. Raise the Risk of Multiple Mycotoxin Occurrence in Chestnuts. Food Microbiol. 2024, 122, 104532. [Google Scholar] [CrossRef]
- Fujii, I.; Yasuoka, Y.; Tsai, H.-F.; Chang, Y.C.; Kwon-Chung, K.J.; Ebizuka, Y. Hydrolytic Polyketide Shortening by Ayg1p, a Novel Enzyme Involved in Fungal Melanin Biosynthesis. J. Biol. Chem. 2004, 279, 44613–44620. [Google Scholar] [CrossRef] [PubMed]
- Pohl, C.; Polli, F.; Schütze, T.; Viggiano, A.; Mózsik, L.; Jung, S.; de Vries, M.; Bovenberg, R.A.L.; Meyer, V.; Driessen, A.J.M. A Penicillium rubens Platform Strain for Secondary Metabolite Production. Sci. Rep. 2020, 10, 7630. [Google Scholar] [CrossRef] [PubMed]
- Piras, M.; Patruno, I.; Nikolakopoulou, C.; Willment, J.A.; Sloan, N.L.; Zanato, C.; Brown, G.D.; Zanda, M. Synthesis of the Fungal Metabolite YWA1 and Related Constructs as Tools to Study MelLec-Mediated Immune Response to Aspergillus Infections. J. Org. Chem. 2021, 86, 6044–6055. [Google Scholar] [CrossRef]
- Park, Y.-I.; Gander, J.E. Choline Derivatives Involved in Osmotolerance of Penicillium fellutanum. Appl. Environ. Microbiol. 1998, 64, 273–278. [Google Scholar] [CrossRef]
- Markham, P.; Robson, G.D.; Bainbridge, B.W.; Trinci, A.P.J. Choline: Its Role in the Growth of Filamentous Fungi and the Regulation of Mycelial Morphology. FEMS Microbiol. Rev. 1993, 10, 287–300. [Google Scholar] [CrossRef]
- Cordero, R.J.B.; Vij, R.; Casadevall, A. Microbial Melanins for Radioprotection and Bioremediation. Microb. Biotechnol. 2017, 10, 1186–1190. [Google Scholar] [CrossRef]
- Gostinčar, C.; Muggia, L.; Grube, M. Polyextremotolerant Black Fungi: Oligotrophism, Adaptive Potential, and a Link to Lichen Symbioses. Front. Microbiol. 2012, 3, 390. [Google Scholar] [CrossRef]
- Morawe, M.; Hoeke, H.; Wissenbach, D.K.; Lentendu, G.; Wubet, T.; Kröber, E.; Kolb, S. Acidotolerant Bacteria and Fungi as a Sink of Methanol-Derived Carbon in a Deciduous Forest Soil. Front. Microbiol. 2017, 8, 1361. [Google Scholar] [CrossRef]
- Gou, J.; Xia, J.; Li, Y.; Qiu, Y.; Jiang, F. A Novel Sulfidogenic Process via Sulfur Reduction to Remove Arsenate in Acid Mine Drainage: Insights into the Performance and Microbial Mechanisms. Water Res. 2024, 254, 121423. [Google Scholar] [CrossRef] [PubMed]
- Johnson, L. Iron and Siderophores in Fungal-Host Interactions. Mycol. Res. 2008, 112, 170–183. [Google Scholar] [CrossRef] [PubMed]
- Xie, B.; Wei, X.; Wan, C.; Zhao, W.; Song, R.; Xin, S.; Song, K. Exploring the Biological Pathways of Siderophores and Their Multidisciplinary Applications: A Comprehensive Review. Molecules 2024, 29, 2318. [Google Scholar] [CrossRef]
- Fomina, M.; Gadd, G.M. Biosorption: Current Perspectives on Concept, Definition and Application. Bioresour. Technol. 2014, 160, 3–14. [Google Scholar] [CrossRef] [PubMed]
- Gadd, G.M. Geomycology: Biogeochemical Transformations of Rocks, Minerals, Metals and Radionuclides by Fungi, Bioweathering and Bioremediation. Mycol. Res. 2007, 111, 3–49. [Google Scholar] [CrossRef]
- Gadd, G.M. Metals, Minerals and Microbes: Geomicrobiology and Bioremediation. Microbiology 2010, 156, 609–643. [Google Scholar] [CrossRef]

| Species | Culture Collection 1 | GenBank Accession Numbers 2 | |||
|---|---|---|---|---|---|
| ITS | BenA | CaM | rpb2 | ||
| Penicillium atramentosum | CBS 291.48 | AF033483 | AY674402 | KU896821 | JN406584 |
| Penicillium balearicum | CBS 143044 | LT899762 | LT898227 | LT899758 | LT899760 |
| Penicillium fimosum | CBS 142991 | – | LT898273 | – | – |
| Penicillium ibericum | CBS 142992 | LT899782 | LT898285 | LT899766 | LT899800 |
| Penicillium magnielliptisporum | CBS 138225 | KJ775686 | KJ775179 | KJ775413 | MN969124 |
| Penicillium mexicanum | CBS 138227 | KJ775685 | KJ775178 | KJ775412 | MN969127 |
| Penicillium mexicanum | Y20P-5 | OQ048471 | OQ130423 | OQ134945 | – |
| Penicillium mexicanum | MUM 23.42 | PP376069 | PP405214 | PP421213 | PP421215 |
| Penicillium mexicanum | MUM 23.43 | PP376070 | PP405215 | PP421214 | PP421216 |
| Penicillium paradoxum | CBS 527.65 | EF669707 | EF669683 | EF669692 | EF669670 |
| Penicillium crystallinum | CBS 479.65 | AF033486 | EF669682 | FJ530973 | EF669669 |
| Penicillium malodoratum | CBS 490.65 | AF033485 | EF669681 | FJ530972 | EF669672 |
| Penicillium sicoris | FMR 18076 | LR884497 | LR884494 | LR884496 | LR884495 |
| Penicillium caprifimosum | CBS 142990 | LT899781 | LT898238 | LT899765 | LT899799 |
| Penicillium bovifimosum | CBS 102825 | AF263347 | KJ834436 | FJ530989 | JN406649 |
| Penicillium turbatum | CBS 383.48 | AF034454 | KJ834499 | KU896853 | JN406556 |
| Penicillium madriti | CBS 347.61 | AF033482 | KJ834470 | EU644076 | JN406561 |
| Info | Value |
|---|---|
| Scaffold number | 22 |
| Total scaffold length | 29,620,091 |
| Average scaffold length | 1,346,367.77 |
| Scaffold N50 | 4,060,673 |
| Scaffold auN | 4,720,784.16 |
| Scaffold L50 | 3 |
| Largest scaffold | 8,180,881 |
| Smallest scaffold | 7668 |
| N’s number | 0 |
| Read mean quality | 14.1 |
| Read median quality | 17.2 |
| Initial number of reads | 155,957 |
| Read mean quality | 14.1 |
| Region | Type | Most Similar Known Cluster | Similarity (%) |
|---|---|---|---|
| Region 2.1 | NRPS | penicillin | 18% |
| Region 3.1 | T1PKS, NRPS-like | lucilactaene | 23% |
| Region 3.2 | T1PKS | ||
| Region 3.3 | T1PKS | ||
| Region 3.4 | terpene | squalestatin S1 | 60% |
| Region 3.5 | NRPS, T1PKS | equisetin | 18% |
| Region 3.6 | T1PKS | andrastin A | 40% |
| Region 3.7 | NRPS | ||
| Region 3.8 | NRP-metallophore, NRPS | ||
| Region 3.9 | T1PKS | monascorubrin | 100% |
| Region 3.10 | NRPS-like, T1PKS | ||
| Region 4.1 | NRPS-like | ||
| Region 4.2 | NRPS-like | ||
| Region 7.1 | T1PKS | gregatin A | 44% |
| Region 7.2 | NRPS | ||
| Region 7.3 | terpene | ||
| Region 7.4 | T1PKS | ||
| Region 7.5 | NRPS | nidulanin A | 75% |
| Region 7.6 | fungal-RiPP-like | ||
| Region 12.1 | indole, NRPS | histidyltryptophanyldiketopiperazine/dehydrohistidyltryptophanyldiketopiperazine/roquefortine D/roquefortine C/glandicoline A/glandicoline B/meleagrine | 100% |
| Region 12.2 | NRPS, T1PKS | YWA1 | 100% |
| Region 12.3 | NRPS-like | choline | 100% |
| Region 18.1 | T1PKS | ||
| Region 20.1 | T1PKS, indole | ||
| Region 20.2 | NRPS-like | ||
| Region 20.3 | betalactone | ||
| Region 21.1 | NRPS-like, fungal-RiPP-like | atpenin B | 54% |
| Region 21.2 | NRPS | ||
| Region 21.3 | NRPS-like | ||
| Region 21.4 | T1PKS | ||
| Region 21.5 | terpene | ||
| Region 21.6 | T1PKS | 4-epi-15-epi-brefeldin A | 20% |
Disclaimer/Publisher’s Note: The statements, opinions and data contained in all publications are solely those of the individual author(s) and contributor(s) and not of MDPI and/or the editor(s). MDPI and/or the editor(s) disclaim responsibility for any injury to people or property resulting from any ideas, methods, instructions or products referred to in the content. |
© 2024 by the authors. Licensee MDPI, Basel, Switzerland. This article is an open access article distributed under the terms and conditions of the Creative Commons Attribution (CC BY) license (https://creativecommons.org/licenses/by/4.0/).
Share and Cite
Trovão, J.; Soares, F.; Paiva, D.S.; Portugal, A. Morpho-Molecular and Genomic Characterization of Penicillium mexicanum Isolates Retrieved from a Forsaken Gold Mine. Appl. Sci. 2024, 14, 10600. https://doi.org/10.3390/app142210600
Trovão J, Soares F, Paiva DS, Portugal A. Morpho-Molecular and Genomic Characterization of Penicillium mexicanum Isolates Retrieved from a Forsaken Gold Mine. Applied Sciences. 2024; 14(22):10600. https://doi.org/10.3390/app142210600
Chicago/Turabian StyleTrovão, João, Fabiana Soares, Diana Sofia Paiva, and António Portugal. 2024. "Morpho-Molecular and Genomic Characterization of Penicillium mexicanum Isolates Retrieved from a Forsaken Gold Mine" Applied Sciences 14, no. 22: 10600. https://doi.org/10.3390/app142210600
APA StyleTrovão, J., Soares, F., Paiva, D. S., & Portugal, A. (2024). Morpho-Molecular and Genomic Characterization of Penicillium mexicanum Isolates Retrieved from a Forsaken Gold Mine. Applied Sciences, 14(22), 10600. https://doi.org/10.3390/app142210600

